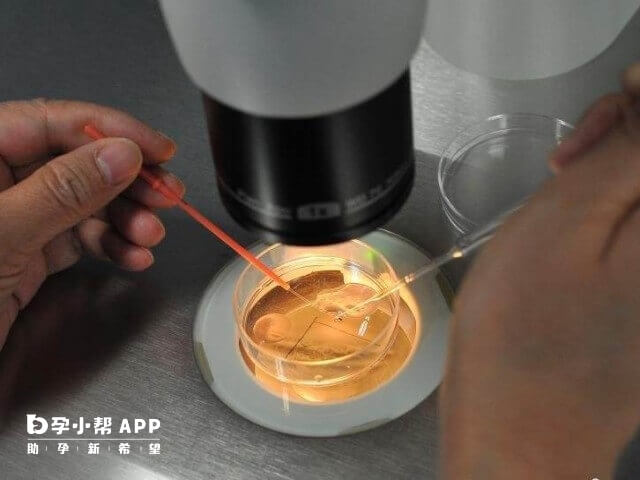

有没有试管婴儿微刺激方案促排到移植的费用明细表?
微刺激方案是使用少量药物进行促排的一种方案,因此在药物上的费用就会大大减少,因此微刺激促排到移植整个流程下来总共需要花费6000到15000元左右,费用主要包括三个方面,身体检查费用、促排药物费用,以及手术费用等,因为每个人患者身体情况不同,选择医院以及使用药物剂量也存在差异,所以费用会有所波动。




白兰国
原创试管婴儿达人 · 广西妇幼二代试管技术
做一次试管微刺激方案从促排到移植会产生的费用包括5000-10000元的促排卵费用、5000元左右的取卵费用、8000元左右的胚胎培养和移植试管婴儿费用,若是选择二代试管助孕的话,需增加一笔5000-8000元左右的精子优化费用,若是选择三代试管助孕的话,需增加一笔30000-50000元左右的胚胎筛查与诊断费用,总的算下来,做一次试管微刺激方案从促排到移植需20000-80000元左右。

微刺激促排到移植费用明细
微刺激方案就是选择小剂量促排卵药物给予卵巢轻微的刺激,主要适用于卵巢功能减退的患者、多囊卵巢综合征患者以及卵巢肿瘤高危患者等患者。一般在利用试管微刺激方案助孕的时候,从促排到移植所需的费用明细大致就如下所列:
1、促排卵费用
试管婴儿微刺激方案常用到的促排卵药物就包括克罗米芬、来曲唑以及尿促性素等等,无论适用哪一品牌的促排卵药物,使用的剂量是比较少的,所需的费用也就比较少,在5000-10000元左右。
2、取卵手术费用
试管微刺激方案促排卵成功之后,即卵巢内70%-80%卵泡达到18mm-25mm取卵标准的时候,医生就会安排扳机,并在扳机后的35-36小时进行取卵手术,这比费用在5000元左右。
3、胚胎培养和移植试管婴儿
在取卵手术的同时,男性也需要取精,然后医生就会将其培养,使其形成胚胎,然后在女性身体适宜的情况的情况就安排移植手术,这比费用在8000元左右。
4、精子优化费用
若是选择二代试管婴儿技术进行助孕的话,在男性取精之后,医生就是用离心机进行精子优化,然后选择单个进行注射,以提高精子和卵子受精的成功率,这比费用在5000-8000元左右。
5、胚胎筛查与诊断费用
若是选择三代试管婴儿技术进行助孕的话,在培养胚胎后移植进行移植手术前,医生会选择质量比较优的胚胎,然后取胚胎遗传物进行筛查与诊断,以剔除质量有问题的胚胎,从而移植无质量问题的胚胎,就能够提高助孕成功率,这比费用在30000-50000元左右。